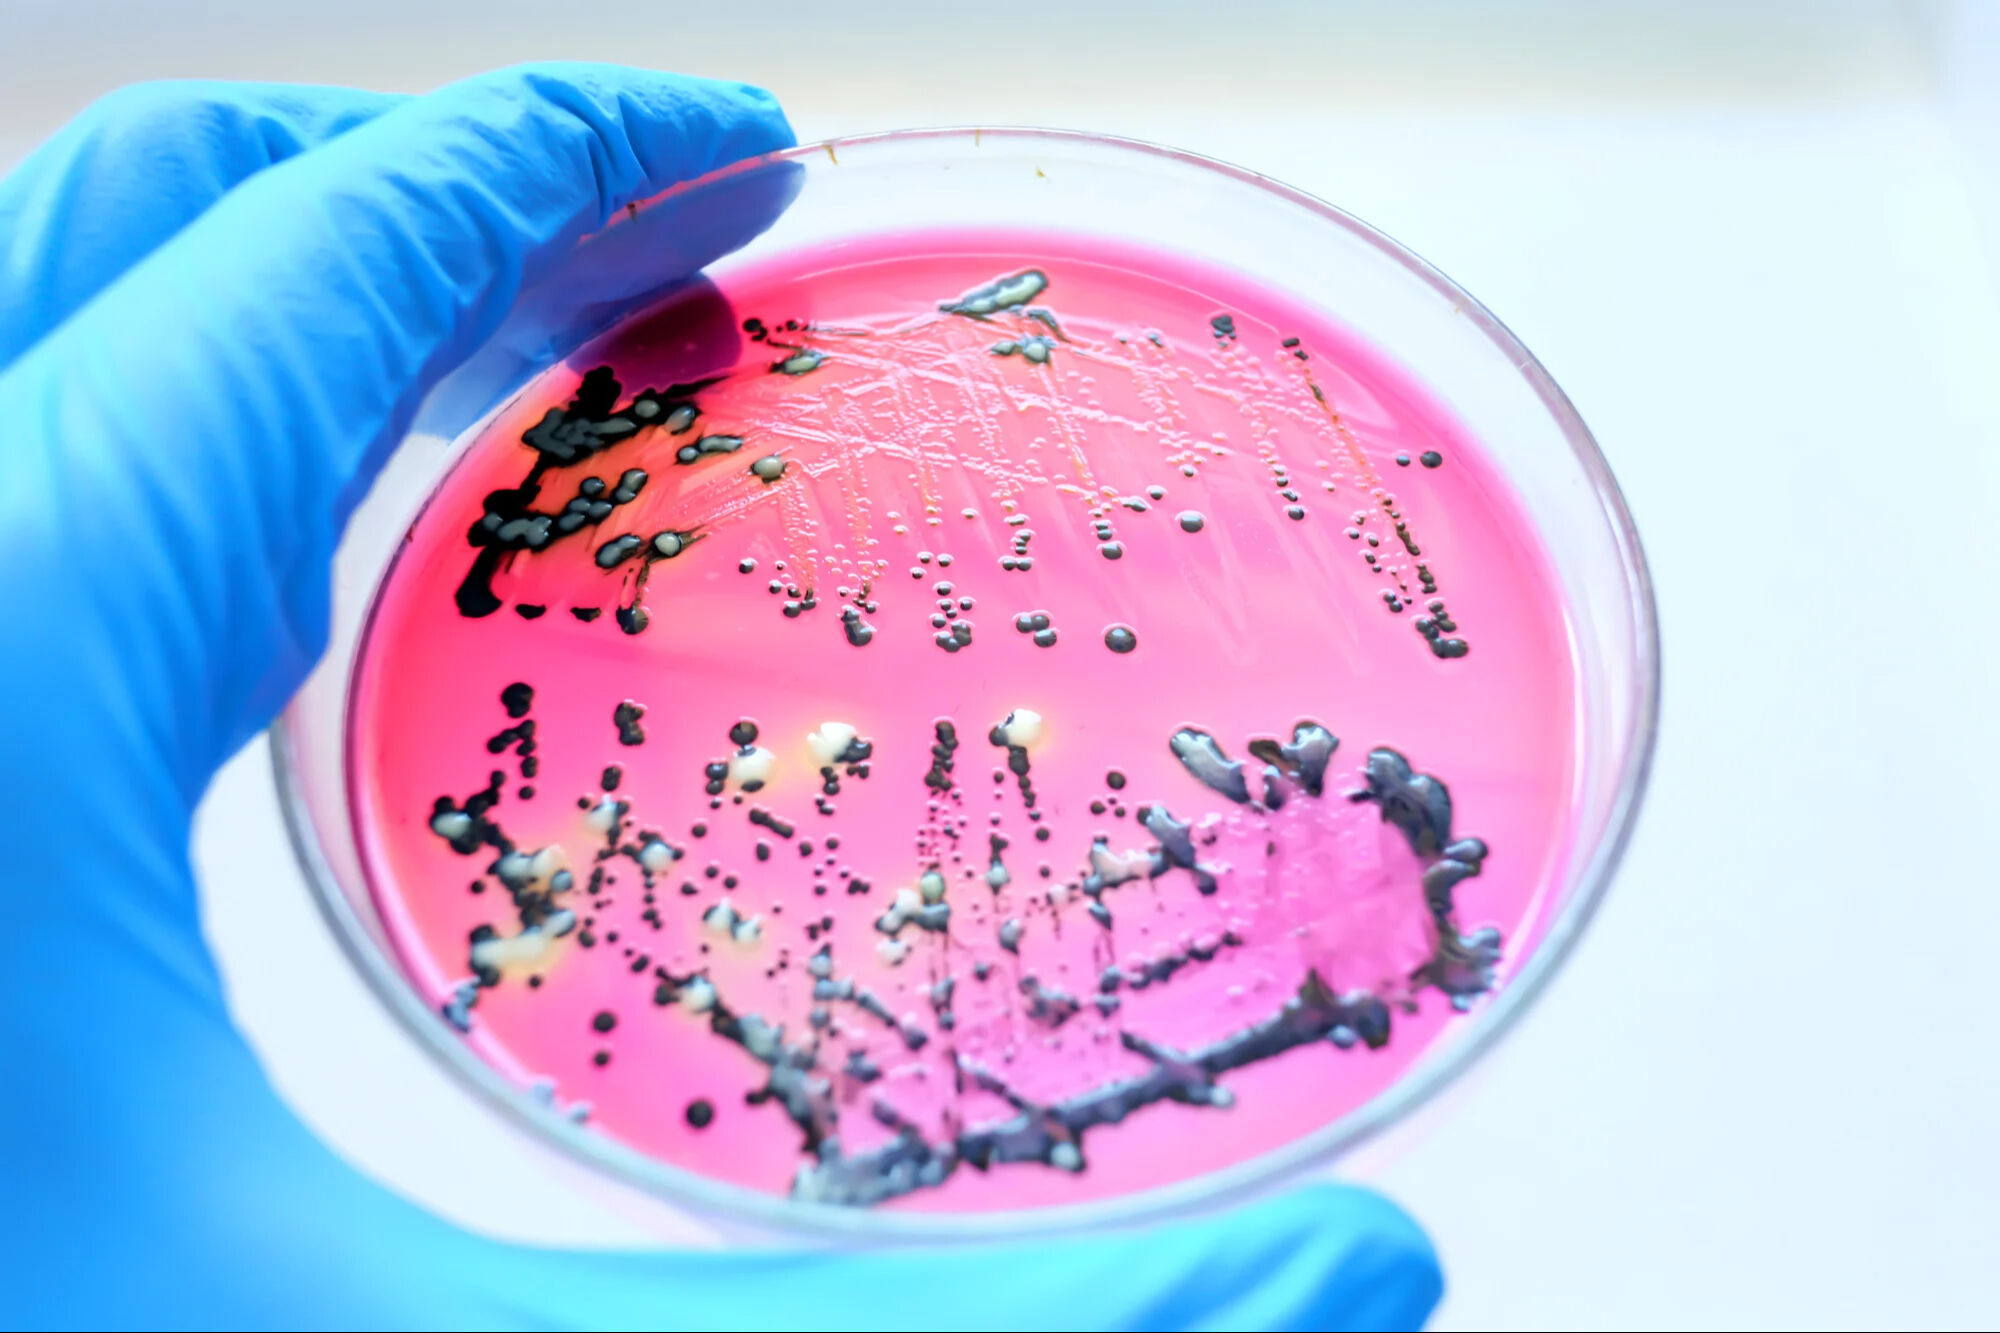
Salmonella nedir, nasıl bulaşır, öldürür mü? Kumpir vakası sonrasında salmonella virüsü, belirtileri, korunma yöntemleri gündemde. - 2. Resim

Salmonella nedir, nasıl bulaşır, öldürür mü? Kumpir vakası sonrasında salmonella virüsü, belirtileri, korunma yöntemleri gündemde.

Salmonella virüsü, gıda zehirlenmesine yol açan tehlikeli bir virüstür. İzmir'de bir vatandaşın kumpirden zehirlenmesi ve ölmesi nedeni salmonella tespit edilmişti. Bu olay sonrasında salmonella korunma yöntemleri aramaları yoğunlaştı.
İzmir Buca'da bir vatandaş, yediği kumpir sonrasında kusma ve ishal şikayetiyle hastaneye başvurdu. Hayatını kaybeden vatandaşın ölümüne sebep olanın salmonella virüsü olduğu anlaşıldı.
Gıda zehirlenmelerinin büyük kısmına neden olan salmonella bulaşması, başta ishal, ateş ve kusma gibi belirtilere sahiptir.
SALMONELLA NEDİR?
Salmonella, tifo, paratifo ve gıda zehirlenmesine yol açabilen, çubuksu, Gram-negatif bir enterobakteri cinsidir. 1885'te keşfedilen ölümcül bakteri, hidrojen sülfür üretir.

NASIL BULAŞIR?
Salmonella enfeksiyonu genellikle çiğ veya az pişmiş et, kümes hayvanları ve yumurta veya yumurtaları ürünleri yemekle veya pastörize edilmemiş süt içmekle bulaşır.
Enfeksiyon, kontamine yiyecek veya suların yenmesi veya içilmesi ya da Salmonella ile enfekte insan veya hayvanlarla temas yoluyla yayılır. Salmonella, çiğ veya az pişmiş et ve yumurtalarda, çiğ (pastörize edilmemiş) süt ve peynir ürünlerinde ve ürünlerde bulunabilir.
Gıdalar, hazırlama veya işleme sırasında da Salmonella bakterileri ile kontamine olabilir.
Enfekte hayvanlarla, özellikle kümes hayvanları (tavuklar, hindiler, ördekler), domuzlar (domuzlar veya domuzlar), sığırlar (inekler), kemirgenler (fareler veya sıçanlar) ve sürüngenler (iguanalar, yılanlar, kertenkeleler ve kaplumbağalar), civcivler, ördek yavruları, kuşlar, köpekler ve kediler gibi evcil hayvanlarla temas enfeksiyonu yayabilir.
SALMONELLOZ KİMLERDE GÖRÜLÜR?
Herhangi bir kişi salmonelloza yakalanabilir, ancak bebeklerde ve çocuklarda daha sık teşhis edilir. Küçük çocuklar, yaşlılar ve bağışıklık sistemi zayıf olanlar (örneğin kanser, HIV/AIDS veya organ nakli olan kişiler) ciddi enfeksiyonlara yakalanma olasılığı en yüksek olanlardır.

SALMONELLOZUN BELİRTİLERİ NELERDİR VE NE ZAMAN ORTAYA ÇIKARLAR?
Salmonellozlu kişilerde hafif veya şiddetli ishal (gevşek dışkı/kaka), mide krampları, ateş ve bazen kusma görülebilir. Kan dolaşımı enfeksiyonları ortaya çıkabilir ve özellikle çok genç veya yaşlılarda oldukça ciddi olabilir. Enfekte olan bazı kişilerde hiçbir belirti görülmez. Belirtiler genellikle Salmonella bakterisiyle temastan birkaç saat ila üç gün sonra ortaya çıkar.
Salmonellozun tedavisi nedir? Salmonelloz genellikle beş ila yedi gün içinde geçer ve enfekte kişi ciddi şekilde susuz kalmadıkça (vücutta su kaybı halsizlik veya baş dönmesine neden olur) veya enfeksiyon bağırsaklardan vücudun diğer bölgelerine yayılmadıkça genellikle tedavi gerektirmez. Şiddetli ishali (gevşek dışkı / kaka) olanlar, genellikle intravenöz sıvılarla rehidrasyon gerektirebilir. Enfeksiyon bağırsaklardan yayılmadığı sürece antibiyotikler genellikle gerekli değildir.

SALMONELLOZ NASIL ÖNLENEBİLİR?
Çiğ kümes hayvanları, sığır etini her zaman uygun şekilde kullanın:
Kan ve meyve sularının diğer gıdalara damlamasını önlemek için taze etleri markette plastik torbalara sarın.
Gıdaları derhal soğutun ve oda sıcaklığında tutmayın.
Pişmiş gıdaları asla daha önce çiğ sığır eti, kümes hayvanları, balık veya deniz ürünleri bulunan yıkanmamış bir yüzeye koymayın.
Sığır eti, kümes hayvanları, balık veya deniz ürünleri hazırlamak için kullanılan kesme tahtaları ve tezgahlar, diğer gıdalarla çapraz bulaşmayı önlemek için kullanımdan hemen sonra yıkanmalıdır.
Çiğ veya az pişmiş etleri yemekten kaçının. Et tamamen piştiğinde meyve suyunun rengi genellikle kırmızıdan griye dönse de, bu etin yenmesinin güvenli olduğunu gösteren güvenilir bir test değildir.
Çiğ yumurta yemekten veya çiğ yumurta içeren gıdaları az pişirmekten kaçının.
Çiğ (pastörize edilmemiş) süt içmekten kaçının.
Meyve ve sebzeleri yemeden önce akan su altında yıkayın.
Gıda hazırlamadan önce ve sonra ellerin sabun ve suyla dikkatlice yıkanmasını teşvik edin.
Sürüngenleri elledikten, evcil hayvan dışkısıyla (kaka) temas ettikten veya evcil hayvan yiyecekleri ya da ikramlarını elledikten hemen sonra ellerinizi (özellikle çocuklar) sabun ve suyla yıkayın.
Civciv ve ördek yavrularının bağırsaklarında taşınan salmonella, çevrelerini ve hayvanın tüm yüzeyini kirletir. Çocuklar sadece kuşları tutarak, kucaklayarak veya öperek bakteriye maruz kalabilirler. Çocuklar yavru civcivleri veya diğer genç kuşları ellememelidir. Yavru civcivler ve ördek yavruları da dahil olmak üzere kuşlara veya çevrelerine dokunduktan sonra herkes derhal ellerini yıkamalıdır.
Sıcaklığı her zaman bir et termometresi ile kontrol edin. Aşağıda listelenen sıcaklıklara veya daha yüksek sıcaklıklara ulaşan yiyecekler tamamen pişmiş demektir
Tavuk 74° C
Hamburger 71° C
Sosisli sandviç 60° C
Yumurta 63° C
Diğer yiyecekler 60° C



















